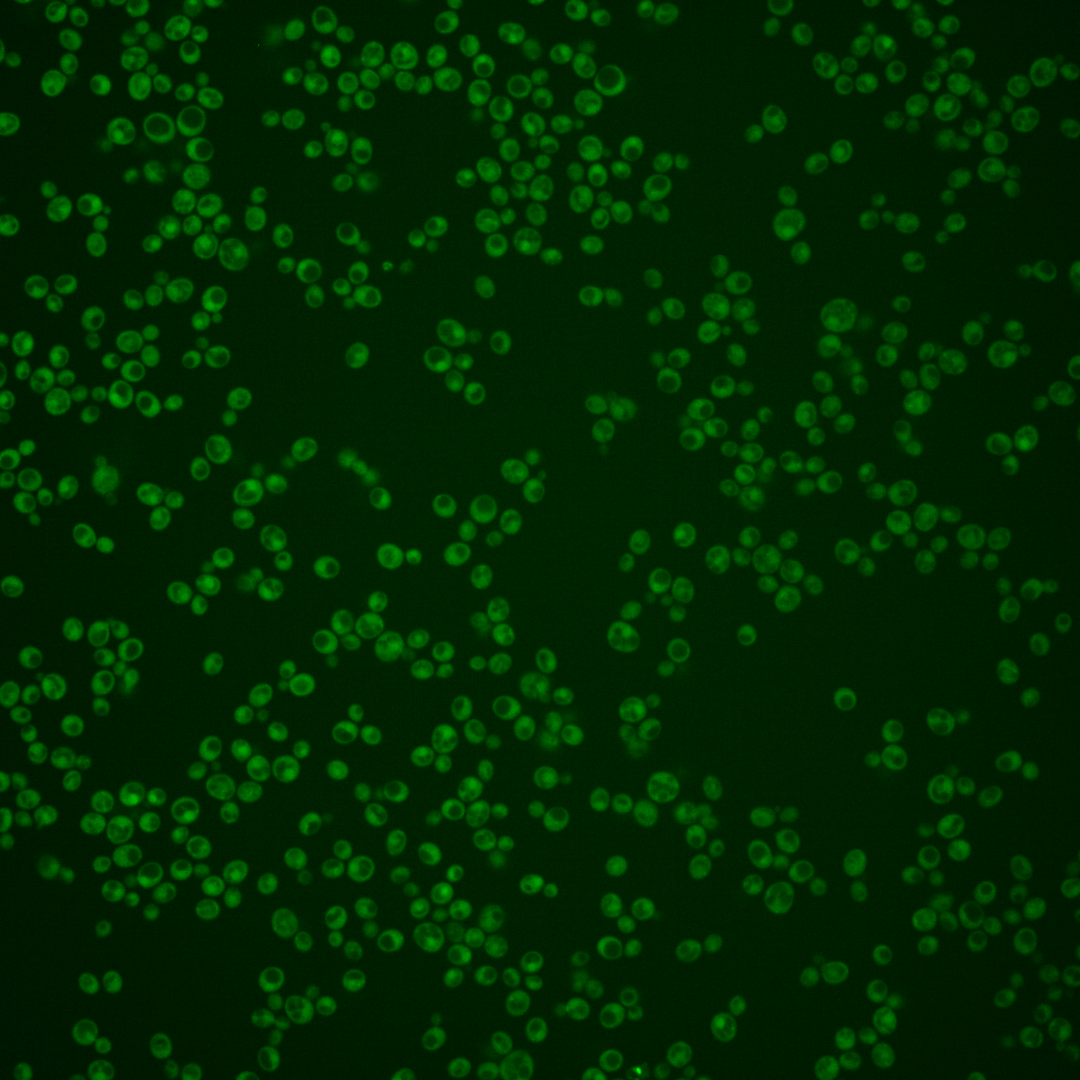
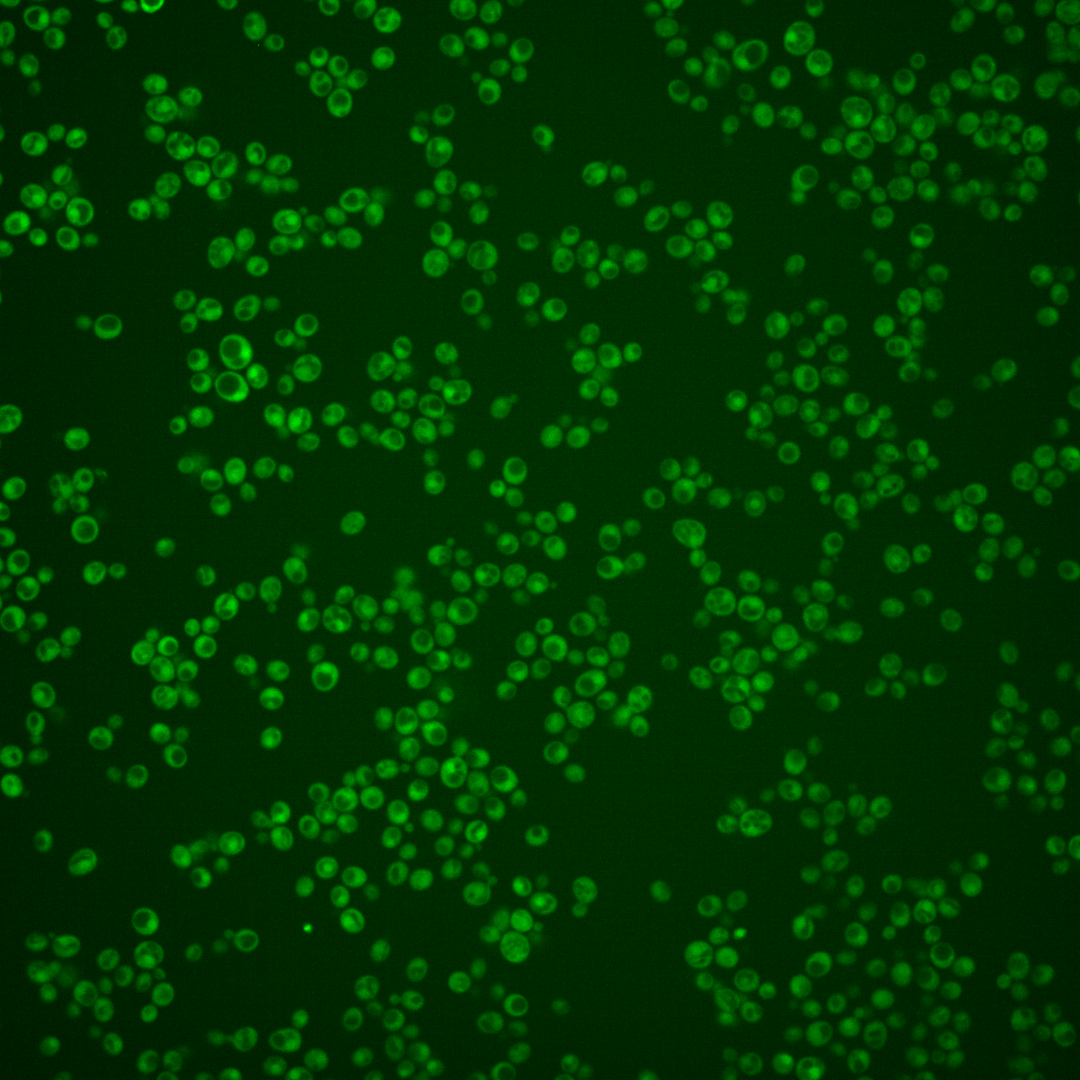
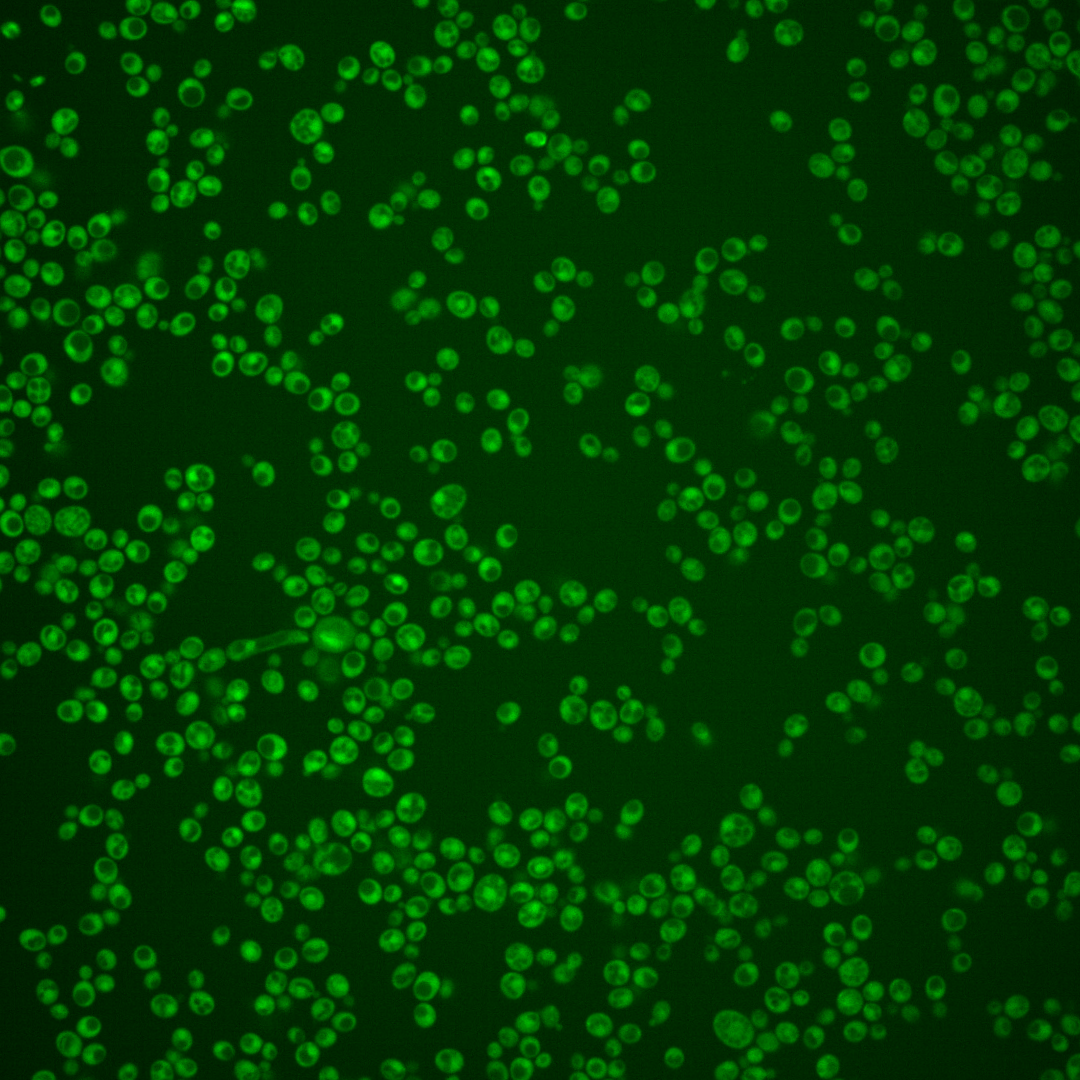
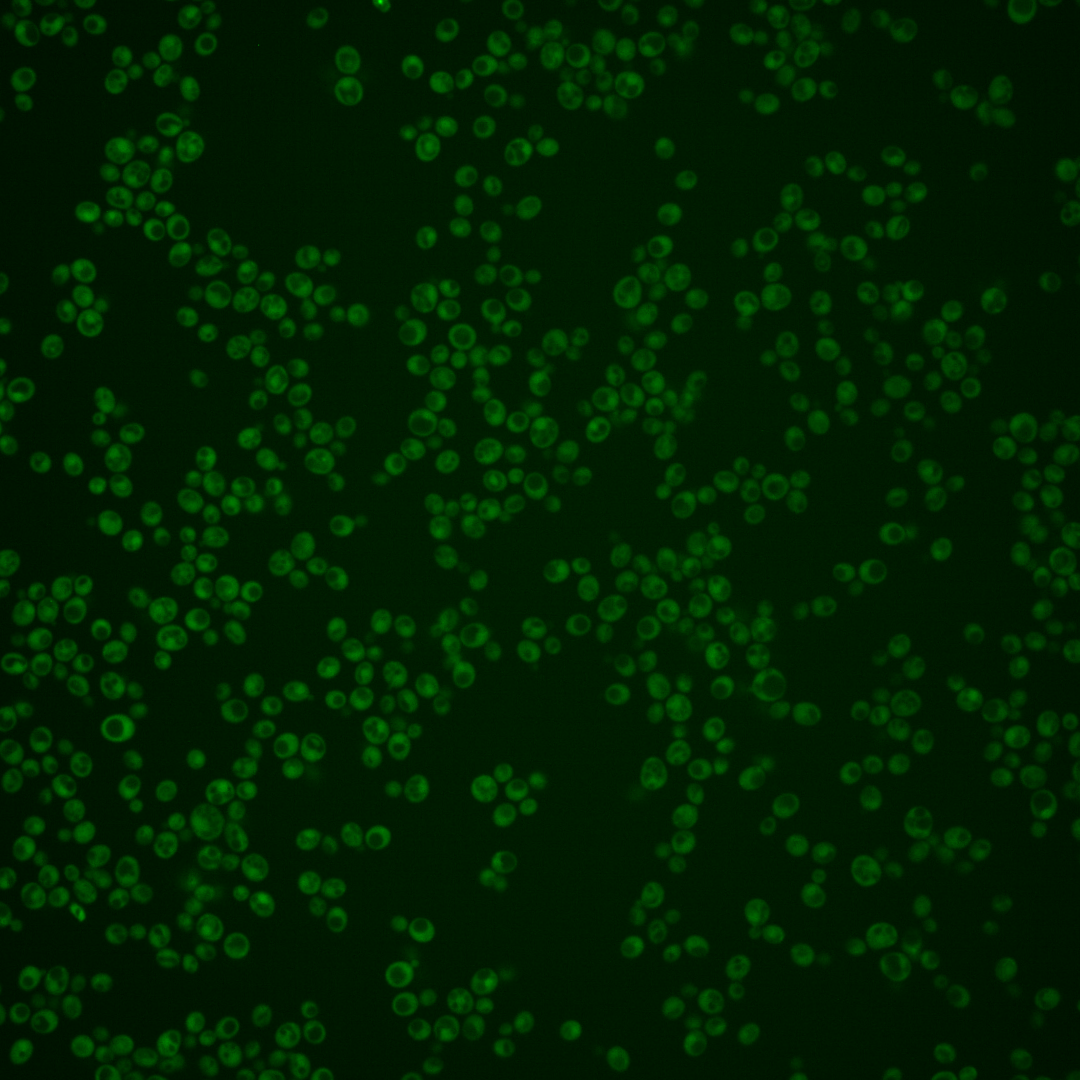

| Standard name | |
|---|---|
| Human Ortholog | |
| Description | Putative cytoplasmic short-chain dehydrogenase/reductase |
Micrographs




















































































Sub-cellular Localization
Yeast GFP Assignment
Protein Abundance
Localization Change
External localization resources
| ensLOC | DeepLoc | |||||||||||||||||||||||
|---|---|---|---|---|---|---|---|---|---|---|---|---|---|---|---|---|---|---|---|---|---|---|---|---|
| Localization | WT1 | WT2 | WT3 | RAP60 | RAP140 | RAP220 | RAP300 | RAP380 | RAP460 | RAP540 | RAP620 | RAP700 | HU80 | HU120 | HU160 | rpd3Δ_1 | rpd3Δ_2 | rpd3Δ_3 | WT1 | WT2 | WT3 | AF100 | AF140 | AF180 |
| Cortical Patches | 0 | 0 | 0 | – | 0 | 0 | 0 | 0 | 0 | 0 | 0 | 0 | 0 | 0 | 0 | 0 | 0 | 0 | 2 | 0 | 0 | 0 | 1 | 3 |
| Bud | 0 | 0 | 0 | – | 0 | 0 | 0 | 1 | 2 | 0 | 2 | 1 | 0 | 0 | 0 | 0 | 0 | 0 | 3 | 4 | 0 | 2 | 0 | 0 |
| Bud Neck | 0 | 0 | 0 | – | 0 | 0 | 0 | 0 | 0 | 0 | 0 | 0 | 0 | 0 | 0 | 0 | 0 | 0 | 0 | 0 | 0 | 0 | 0 | 1 |
| Bud Site | 0 | 0 | 0 | – | 0 | 0 | 0 | 0 | 0 | 0 | 0 | 0 | 0 | 0 | 0 | 0 | 0 | 0 | – | – | – | – | – | – |
| Cell Periphery | 3 | 1 | 0 | – | 0 | 1 | 0 | 0 | 0 | 0 | 1 | 0 | 0 | 0 | 0 | 1 | 5 | 2 | 0 | 0 | 0 | 0 | 0 | 0 |
| Cytoplasm | 360 | 487 | 16 | – | 19 | 109 | 135 | 161 | 77 | 71 | 95 | 60 | 203 | 173 | 275 | 150 | 168 | 154 | 334 | 467 | 39 | 159 | 222 | 192 |
| Endoplasmic Reticulum | 1 | 2 | 0 | – | 0 | 2 | 0 | 0 | 0 | 1 | 0 | 0 | 0 | 0 | 0 | 11 | 4 | 5 | 0 | 0 | 0 | 1 | 1 | 1 |
| Endosome | 0 | 1 | 0 | – | 0 | 0 | 2 | 0 | 0 | 0 | 2 | 0 | 2 | 0 | 0 | 0 | 0 | 1 | 2 | 1 | 0 | 3 | 0 | 2 |
| Golgi | 3 | 1 | 0 | – | 0 | 0 | 0 | 0 | 0 | 0 | 0 | 0 | 0 | 0 | 0 | 1 | 0 | 0 | 4 | 2 | 0 | 0 | 0 | 0 |
| Mitochondria | 5 | 4 | 0 | – | 1 | 5 | 10 | 14 | 41 | 30 | 60 | 46 | 2 | 0 | 1 | 2 | 2 | 1 | 3 | 5 | 0 | 3 | 1 | 5 |
| Nucleus | 2 | 2 | 0 | – | 0 | 5 | 3 | 3 | 2 | 3 | 4 | 6 | 0 | 1 | 0 | 1 | 1 | 3 | 1 | 0 | 0 | 2 | 0 | 0 |
| Nuclear Periphery | 0 | 2 | 0 | – | 0 | 0 | 1 | 0 | 0 | 0 | 0 | 1 | 0 | 0 | 0 | 0 | 0 | 0 | 0 | 0 | 0 | 0 | 0 | 0 |
| Nucleolus | 0 | 0 | 1 | – | 0 | 0 | 0 | 0 | 0 | 0 | 0 | 0 | 0 | 0 | 0 | 0 | 0 | 0 | 0 | 0 | 0 | 0 | 0 | 0 |
| Peroxisomes | 0 | 0 | 0 | – | 0 | 0 | 0 | 0 | 0 | 0 | 0 | 0 | 0 | 0 | 0 | 0 | 0 | 0 | 0 | 0 | 0 | 0 | 0 | 0 |
| SpindlePole | 0 | 0 | 0 | – | 0 | 0 | 0 | 0 | 0 | 0 | 0 | 0 | 0 | 1 | 0 | 0 | 0 | 0 | 1 | 0 | 0 | 1 | 4 | 2 |
| Vac/Vac Membrane | 1 | 2 | 0 | – | 0 | 0 | 15 | 19 | 3 | 3 | 8 | 14 | 2 | 0 | 2 | 3 | 12 | 13 | 1 | 2 | 0 | 3 | 2 | 3 |
| Unique Cell Count | 367 | 496 | 17 | 19 | 114 | 155 | 186 | 105 | 91 | 147 | 110 | 207 | 174 | 276 | 154 | 180 | 162 | 360 | 488 | 42 | 183 | 241 | 222 | |
| Labelled Cell Count | 375 | 502 | 17 | 20 | 122 | 166 | 198 | 125 | 108 | 172 | 128 | 209 | 175 | 278 | 169 | 192 | 179 | 360 | 488 | 42 | 183 | 241 | 222 | |
Yeast GFP Assignment
Protein Abundance
| Screen | WT1 | WT2 | WT3 | RAP60 | RAP140 | RAP220 | RAP300 | RAP380 | RAP460 | RAP540 | RAP620 | RAP700 | HU80 | HU120 | HU160 | rpd3Δ_1 | rpd3Δ_2 | rpd3Δ_3 | AF100 | AF140 | AF180 |
|---|---|---|---|---|---|---|---|---|---|---|---|---|---|---|---|---|---|---|---|---|---|
| Mean Cell GFP Intensity (1e-4) | 5.1 | 4.4 | 5.1 | – | 4.2 | 5.1 | 5.7 | 6.0 | 4.9 | 5.0 | 5.3 | 5.4 | 6.1 | 6.3 | 5.5 | 7.1 | 8.8 | 9.2 | 6.8 | 6.9 | 6.7 |
| Std Deviation (1e-4) | 1.1 | 0.8 | 0.4 | – | 1.0 | 1.0 | 1.5 | 1.4 | 1.2 | 0.9 | 1.3 | 1.2 | 1.4 | 1.3 | 1.2 | 1.3 | 1.7 | 1.6 | 1.7 | 1.6 | 1.7 |
| Intensity Change (Log2) | – | – | – | – | -0.27 | 0.0 | 0.17 | 0.24 | -0.07 | -0.01 | 0.05 | 0.08 | 0.27 | 0.31 | 0.12 | 0.48 | 0.79 | 0.86 | 0.41 | 0.43 | 0.41 |
Localization Change
| Localization | RAP60 | RAP140 | RAP220 | RAP300 | RAP380 | RAP460 | RAP540 | RAP620 | RAP700 | HU80 | HU120 | HU160 | rpd3Δ_1 | rpd3Δ_2 | rpd3Δ_3 |
|---|---|---|---|---|---|---|---|---|---|---|---|---|---|---|---|
| Actin | – | – | – | – | – | – | – | – | – | – | – | – | – | – | – |
| Bud | – | – | – | – | – | – | – | – | – | – | – | – | – | – | – |
| Bud Neck | – | – | – | – | – | – | – | – | – | – | – | – | – | – | – |
| Bud Site | – | – | – | – | – | – | – | – | – | – | – | – | – | – | – |
| Cell Periphery | – | – | – | – | – | – | – | – | – | – | – | – | – | – | – |
| Cyto | – | – | – | – | – | – | – | – | – | – | – | – | – | – | – |
| Endoplasmic Reticulum | – | – | – | – | – | – | – | – | – | – | – | – | – | – | – |
| Endosome | – | – | – | – | – | – | – | – | – | – | – | – | – | – | – |
| Golgi | – | – | – | – | – | – | – | – | – | – | – | – | – | – | – |
| Mitochondria | – | – | – | – | – | – | – | – | – | – | – | – | – | – | – |
| Nuclear Periphery | – | – | – | – | – | – | – | – | – | – | – | – | – | – | – |
| Nuc | – | – | – | – | – | – | – | – | – | – | – | – | – | – | – |
| Nucleolus | – | – | – | – | – | – | – | – | – | – | – | – | – | – | – |
| Peroxisomes | – | – | – | – | – | – | – | – | – | – | – | – | – | – | – |
| SpindlePole | – | – | – | – | – | – | – | – | – | – | – | – | – | – | – |
| Vac | – | – | – | – | – | – | – | – | – | – | – | – | – | – | – |
| Cortical Patches | – | – | – | – | – | – | – | – | – | – | – | – | – | – | – |
| Cytoplasm | – | – | – | – | – | – | – | – | – | – | – | – | – | – | – |
| Nucleus | – | – | – | – | – | – | – | – | – | – | – | – | – | – | – |
| Vacuole | – | – | – | – | – | – | – | – | – | – | – | – | – | – | – |
External localization resources
Images






























Protein Concentration and Protein Localization Data
| R1 | R2 | R3 | ||||||||||||||||
|---|---|---|---|---|---|---|---|---|---|---|---|---|---|---|---|---|---|---|
| G1 Pre-START | G1 Post-START | S/G2 | Metaphase | Anaphase | Telophase | G1 Pre-START | G1 Post-START | S/G2 | Metaphase | Anaphase | Telophase | G1 Pre-START | G1 Post-START | S/G2 | Metaphase | Anaphase | Telophase | |
| Concentration | 1.6582 | 2.68 | 2.4644 | 2.2549 | 2.1715 | 2.378 | 8.0813 | 8.5553 | 8.8724 | 7.7468 | 8.5418 | 8.5042 | 4.7921 | 5.6426 | 5.4116 | 5.8643 | 5.3287 | 5.3343 |
| Actin | 0.0002 | 0.0007 | 0.0026 | 0.0004 | 0.0022 | 0.0015 | 0.03 | 0.0015 | 0.0095 | 0.0072 | 0.0552 | 0.0078 | 0.0118 | 0.0041 | 0.0076 | 0.0513 | 0.0068 | 0.0008 |
| Bud | 0.0002 | 0.0031 | 0.0106 | 0.0006 | 0.0011 | 0.0035 | 0.0065 | 0.0012 | 0.0024 | 0.002 | 0.0002 | 0.0008 | 0.0005 | 0.0008 | 0.0006 | 0.0006 | 0.0023 | 0.0002 |
| Bud Neck | 0.0003 | 0.0003 | 0.0004 | 0.0003 | 0.0007 | 0.0025 | 0.0185 | 0.0005 | 0.0029 | 0.0009 | 0.0016 | 0.0013 | 0.0006 | 0.0007 | 0.0003 | 0.0007 | 0.0056 | 0.0009 |
| Bud Periphery | 0.0001 | 0.0005 | 0.0026 | 0.0004 | 0.001 | 0.0016 | 0.0092 | 0.0004 | 0.0028 | 0.002 | 0.0002 | 0.001 | 0.0007 | 0.0007 | 0.0005 | 0.0003 | 0.0034 | 0.0001 |
| Bud Site | 0.0005 | 0.0051 | 0.0023 | 0.0003 | 0.0006 | 0.0036 | 0.0094 | 0.0047 | 0.0061 | 0.002 | 0.0004 | 0.0005 | 0.0018 | 0.0034 | 0.0006 | 0.0009 | 0.0094 | 0.0001 |
| Cell Periphery | 0 | 0.0002 | 0.0001 | 0 | 0.0001 | 0.0002 | 0.0008 | 0.0001 | 0.0003 | 0.0002 | 0 | 0.0001 | 0.0002 | 0.0002 | 0.0001 | 0.0001 | 0.0002 | 0.0001 |
| Cytoplasm | 0.8075 | 0.8197 | 0.8297 | 0.8242 | 0.8293 | 0.8581 | 0.5464 | 0.8832 | 0.7255 | 0.7721 | 0.6859 | 0.8095 | 0.7872 | 0.8985 | 0.8421 | 0.7666 | 0.8098 | 0.8799 |
| Cytoplasmic Foci | 0.0115 | 0.0073 | 0.0092 | 0.0108 | 0.0165 | 0.0112 | 0.046 | 0.0058 | 0.0223 | 0.0386 | 0.0289 | 0.0167 | 0.0269 | 0.0044 | 0.0082 | 0.0484 | 0.0376 | 0.014 |
| Eisosomes | 0 | 0 | 0 | 0 | 0 | 0 | 0.0005 | 0 | 0.0001 | 0.0001 | 0.0002 | 0.0001 | 0.0001 | 0.0001 | 0 | 0.0002 | 0.0001 | 0 |
| Endoplasmic Reticulum | 0.0037 | 0.0029 | 0.0043 | 0.0041 | 0.0067 | 0.0031 | 0.0096 | 0.002 | 0.0027 | 0.0056 | 0.0014 | 0.0028 | 0.0047 | 0.0018 | 0.0029 | 0.0019 | 0.004 | 0.0026 |
| Endosome | 0.0058 | 0.0038 | 0.0043 | 0.0073 | 0.0091 | 0.0051 | 0.0378 | 0.0024 | 0.0186 | 0.0174 | 0.0041 | 0.007 | 0.0101 | 0.0012 | 0.0046 | 0.0091 | 0.0203 | 0.003 |
| Golgi | 0.0004 | 0.0002 | 0.0003 | 0.0003 | 0.0004 | 0.0016 | 0.0109 | 0.0003 | 0.0087 | 0.0163 | 0.0009 | 0.0023 | 0.0016 | 0.0004 | 0.0013 | 0.0058 | 0.0073 | 0.0003 |
| Lipid Particles | 0.0006 | 0.0001 | 0.0002 | 0.0001 | 0.0006 | 0.0013 | 0.0071 | 0.0001 | 0.0095 | 0.0072 | 0.0004 | 0.0016 | 0.0015 | 0.0003 | 0.0032 | 0.0046 | 0.0165 | 0.0001 |
| Mitochondria | 0.0004 | 0.0003 | 0.0011 | 0.0005 | 0.0007 | 0.0011 | 0.027 | 0.0003 | 0.0073 | 0.0095 | 0.0002 | 0.0022 | 0.0011 | 0.0003 | 0.0005 | 0.0011 | 0.0035 | 0.0008 |
| None | 0.1486 | 0.1354 | 0.1093 | 0.1335 | 0.1118 | 0.0869 | 0.1841 | 0.088 | 0.1599 | 0.0941 | 0.1898 | 0.122 | 0.1194 | 0.0761 | 0.1111 | 0.0436 | 0.0311 | 0.0856 |
| Nuclear Periphery | 0.002 | 0.0038 | 0.0035 | 0.0028 | 0.0024 | 0.0017 | 0.0227 | 0.0012 | 0.0015 | 0.0025 | 0.0007 | 0.004 | 0.011 | 0.0009 | 0.0024 | 0.0025 | 0.0071 | 0.001 |
| Nucleolus | 0.0003 | 0.0001 | 0.0002 | 0.0001 | 0.0002 | 0.0002 | 0.0009 | 0.0001 | 0.0004 | 0.0007 | 0.0002 | 0.0001 | 0.0004 | 0.0001 | 0.0001 | 0.0004 | 0.0016 | 0 |
| Nucleus | 0.0063 | 0.0128 | 0.0119 | 0.0088 | 0.0105 | 0.0109 | 0.0082 | 0.0062 | 0.0041 | 0.0077 | 0.0027 | 0.0054 | 0.0084 | 0.0038 | 0.0047 | 0.0051 | 0.0078 | 0.0072 |
| Peroxisomes | 0.0008 | 0.0003 | 0.0003 | 0.0001 | 0.0003 | 0.0008 | 0.0121 | 0.0003 | 0.0101 | 0.006 | 0.0009 | 0.0104 | 0.0032 | 0.0005 | 0.0022 | 0.0075 | 0.0072 | 0.0003 |
| Punctate Nuclear | 0.0089 | 0.0012 | 0.0054 | 0.0012 | 0.0026 | 0.0037 | 0.0049 | 0.0009 | 0.0024 | 0.0041 | 0.0257 | 0.0032 | 0.0061 | 0.0009 | 0.006 | 0.0484 | 0.0148 | 0.002 |
| Vacuole | 0.0017 | 0.0018 | 0.0014 | 0.0036 | 0.0027 | 0.0013 | 0.0051 | 0.0008 | 0.0024 | 0.0032 | 0.0004 | 0.0009 | 0.0021 | 0.0007 | 0.0008 | 0.0006 | 0.0026 | 0.0006 |
| Vacuole Periphery | 0.0002 | 0.0003 | 0.0003 | 0.0007 | 0.0004 | 0.0003 | 0.0023 | 0.0001 | 0.0005 | 0.0008 | 0.0001 | 0.0004 | 0.0008 | 0.0001 | 0.0002 | 0.0003 | 0.001 | 0.0002 |
Sequencing Data
| R1 | R2 | |||||||||
|---|---|---|---|---|---|---|---|---|---|---|
| G1 Post-START | S/G2 | Metaphase | Anaphase | Telophase | G1 Post-START | S/G2 | Metaphase | Anaphase | Telophase | |
| Gene Expression | 31.0107 | 21.9195 | 25.833 | 29.2858 | 32.7264 | 28.8312 | 38.7848 | 22.4375 | 33.5291 | 32.667 |
| Translational Efficiency | 1.3308 | 2.176 | 1.8489 | 1.3998 | 1.4816 | 1.2339 | 0.9173 | 1.8618 | 1.0729 | 0.9728 |
Hit Data
| Dataset | Hit |
|---|---|
| Protein Concentration | ✔ |
| Protein Localization | ✘ |
| Gene Expression | ✘ |
| Translational Efficiency | ✘ |
Endocytosis
| Temp | Actin Patch (Sac6-tdTomato) | Cortical Patch (Sla1-GFP) | Late Endosome (Snf7-GFP) | Vacuole (Vph1-GFP) |
|---|---|---|---|---|
| 37℃ | ||||
| RT |
Cell Cycle Omics
CYCLoPs (Nre1-GFP)
| Gene / Allele | Actin Patch (Sac6-tdTomato) | Cortical Patch (Sla1-GFP) | Late Endosome (Snf7-GFP) | Vacuole (Sac6-tdTomato) |
|---|
| Gene | Images |
|---|
| Gene | Images |
|---|
Images are not yet available
Images are not yet available